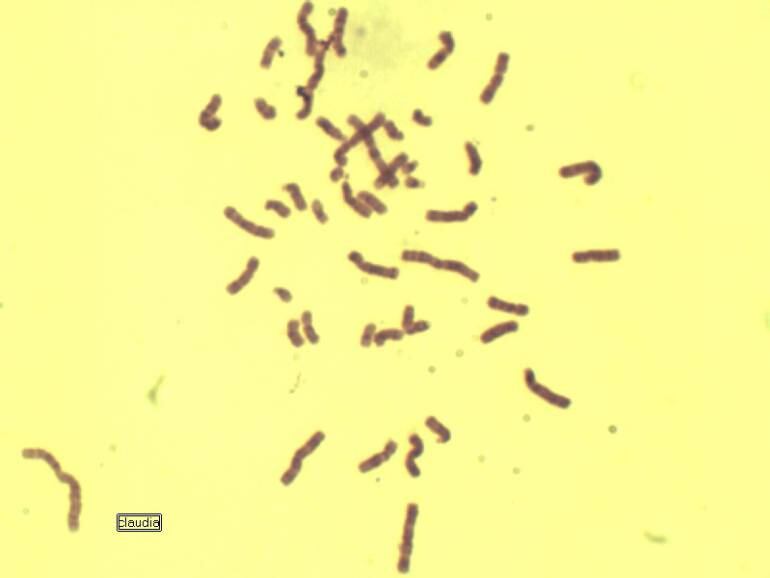

Síndrome de Turner, una enfermedad cromosómica que afecta a las mujeres
El Síndrome de Turner es una patología de origen genético que afecta a la población femenina y se caracteriza por la ausencia del cromosoma X. Este trastorno impacta el desarrollo sexual y el crecimiento de las pacientes.

(Flickr: C.C. cl a ra maría inés)
El síndrome de Turner es una patología de origen genético que afecta a la población femenina y se caracteriza por la ausencia del cromosoma X. Este trastorno impacta el desarrollo sexual y el crecimiento de las pacientes.
“Es la anomalía cromosómica más frecuente en niñas (1 de cada 2500 recién nacidas vivas aproximadamente), en la cual se encuentra ausente uno de los dos cromosomas X”, indicó la endocrinóloga Estefanía Pinzón.
Según la directora científica de la Fundación Síndrome de Turner Colombia, María Victoria Lopera, “dentro de las principales complicaciones de este síndrome están la talla baja, problemas cardiovasculares, renales y hepáticos, cuello palmeado, paladar hendido, osteoporosis, alteraciones en el comportamiento y dificultades cognitivas-conductuales, entre otras”.
Precisamente es la Fundación Síndrome de Turner Colombia, con sede principal en Medellín, la organización que más ha trabajado por mejorar la atención en salud y generar espacios de acompañamiento para las pacientes con esta enfermedad en el país. Desde el 2011 iniciaron labores por iniciativa del doctor Vital Baltazar y la doctora María Victoria Lopera.
Su principal objetivo es asesorar a pacientes y cuidadores frente a trámites, tratamientos, terapias ante las diferentes entidades de salud, asesoría médica y psicológica. De acuerdo con Juli Guevara, presidenta de la Fundación, el reto más importante alcanzado en estos 6 años como organización sin ánimo de lucro, ha sido la inclusión de esta patología dentro del grupo de enfermedades raras o huérfanas, permitiendo así mayor cobertura e inclusión para las pacientes. Actualmente cuentan con un promedio de 350 pacientes atendidas, en diferentes ciudades del país.
Consecuencias del Síndrome de Turner
De acuerdo con la endocrinóloga, la Dra. Pinzón, “a pesar de la perseverancia y el deseo de superación de las pacientes, el día a día se convierte en todo un desafío, pues afrontar la talla baja, la dificultades de fertilidad y las barreras para estudiar y trabajar, son condiciones que deterioran su salud física y emocional”.
“Un diagnóstico temprano y un adecuado tratamiento permite a muchas niñas con Síndrome de Turner tener un crecimiento y una maduración sexual relativamente normal” afirmó la especialista.
Tratamientos
Según la endocrinóloga, “el seguimiento del especialista en esta enfermedad es necesario durante toda la vida de las pacientes, inicialmente con el pediatra endocrinólogo y luego con el endocrinólogo de adultos cuando llegan a la edad adulta; se busca con ello, mantener el pronóstico en su talla (la cual puede ser hasta -18 cm de lo esperado), iniciar la pubertad de manera saludable y evaluar la posibilidad de fertilidad; ello desde el punto de vista hormonal. Así mismo deben estar en constante observación multidisciplinaria para tratar posibles problemas cardíacos, otitis, entre otros”.
Para finalizar la doctora Pinzón afirma que “el Síndrome de Turner puede pasar desapercibido hasta los 6 a 10 años, y manifestarse inicialmente como talla baja, por lo cual, el cariotipo (examen que se hace para identificar anomalías cromosómicas como causa de una malformación o de una enfermedad) se debe realizar a criterio médico a las niñas diagnosticadas con talla baja, por ser una alteración tan frecuente.
El objetivo es mantener la calidad de vida de las niñas, evitando las posibles alteraciones endocrinológicas como consecuencia del mismo, instaurando los tratamientos requeridos. Por otra parte, el control multidisciplinario: cardiología, otorrino, gastroenterología, etc. permitirá el seguimiento y adecuado control de las alteraciones en otros órganos y sistemas”.
Testimonio - Julieth Ruge Guevara
Una paciente con Síndrome de Turner, diagnosticada a los 9 años. Hoy en día cuenta con 24 años de edad, y según sus declaraciones en el transcurso de estos 15 años ha tenido cambios en su vida, de tipo emocional, físico y mental; de acuerdo con Julieth, desde que fue diagnosticada ha tenido que pasar por múltiples centros médicos y probar distintas terapias para mejorar su salud y su calidad de vida.
Hoy en día asegura que cuenta con una vida estable, se encuentra estudiando derecho e indica que la atención médica y el apoyo de su mamá, Juli Guevara, y de la fundación Síndrome de Turner Colombia, ha sido fundamental para su vida y para su relacionamiento con la sociedad en general.




